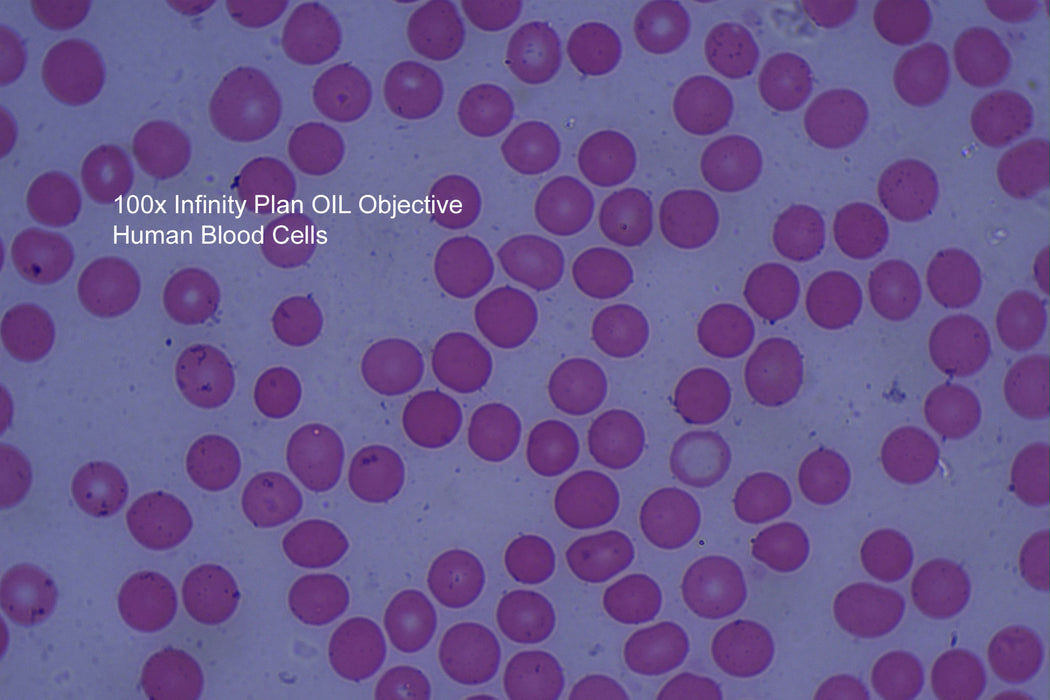

BM2000 With 100X DRY Objective - NEVER Use OIL Again
BM2000 Laboratory Microscope with Infinity Plan Optical System
The BM2000 is our flagship microscope, having been ergonomically designed specifically for extended use in the laboratory for biological, histological, pathological, bacteriological, immunization, and veterinary fields. The included 4x, 10x, 40x & 100x DRY Infinity Plan Objectives produce a flat image across the field of view and perfect clarity.
All controls are easily accessible and comfortable when used for extended periods of observation. The new 3W LED-LUX illumination system is the best solution to provide pure, intense white light even using the higher magnification objectives.
A unique feature of the BM2000 is the advanced XY stage design to ensure all the moving parts are concealed within the stage plate, as shown.
BUNDLE DEAL also available to include the Digital Camera SAVE $740
Tired of cleaning oil off your 100x Objective?
The new 100x DRY INFINITY PLAN objective will make your work procedure faster and more productive. NEVER use oil again.
- No more cleaning oil from the 100x objective again
- No more contamination of the 40x objective with oil
- No need to buy immersion oil ever again
- No more wiping oil off a slide and cleaning again
- Less frequent servicing of your microscope
- Increased work efficiency faster scanning of slides
- Cleaner working environment
- Save time and money
The frustration we hear from vets many times is the blocking up of their 100x oil immersion lens with old oil and the contamination of the 40x dry objective. After an extended period of time, if the oil isnt cleaned off the lens after every use, the immersion oil can penetrate deep into the lens and require expert cleaning or, in some cases, the replacement of the objective completely. Now your frustration is over; try our new 100x dry objective.
Specification:
- Optical System: Infinity Plan Achromatic Objective 4×, 10×, 40×, 100x DRY
- Viewing Head: Seidentopf Trinocular Viewing Head, Inclined at 30°, 360° Rotatable, Interpupillary 48-75mm
- Eyepieces: WF10×/20
- Nosepiece: Backward Quadruple Nosepiece
- Focusing: Coaxial Coarse & Fine Adjustment, Fine Division 0.002mm, Coarse Stroke 37.7mm per Rotation, Fine Stroke 0.2mm per Rotation, Moving Range 22mm
- Stage: Rectangular 216×150mm, Cross Travel 78×54mm, Using Low-positioned X/Y Coaxial Control Knob.
- Condenser: Abbe Condenser NA1.25 with Aperture Diaphragm
- Illumination: 3W LED Illumination System